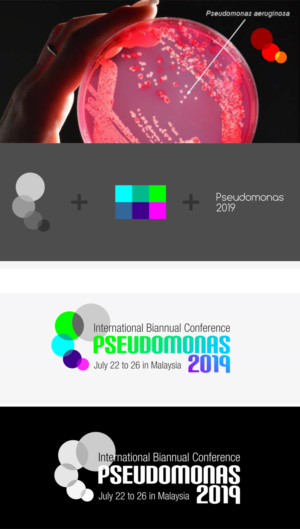
Logo-Design von uk für Florida International University | Design: #18255745

Pseudomonas 2019
Pseudomonas 2019 wollte ein logo design und hat 11 Elegant, Spielerisch logo designs von 6 Designers bekommen
11
Designs
6
Designer
$120
Budget
1 - 11 von 11 Logo-Designs Vorschläge
Hier ist was Pseudomonas 2019 suchte für sein logo design.
We need a logo design for the International Biannual Pseudomonas Conference that will be held in Malaysia in 2019.
The dates of the conferenceare J...
Mehr lesen